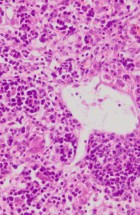

Head of Department
Dr. Sci. Vet. Med. Božidar Savić, principal research fellow
Associates at the Department
Dr. Sci. Vet. Med. Branislav Kureljušić, principal research fellow
Dr. Sci. Vet. Med. Nemanja Jezdimirović, senior research associate
Dr. Vet. Med. Bojan Milovanović
Technical Staff
Miloš Radulović, veterinary technician
The Department’s main activities encompass research and specialized tasks. It focuses on clinical, pathoanatomical, pathohistological, immunohistochemical, and molecular diagnostics of diseases in both domestic and wild animals, including reproductive pathology. Operations within the department are structured around fieldwork and laboratory analyses.
Department Activities:
- Conducting pathoanatomical diagnoses (autopsies) on domestic and wild animals.
- Performing pathohistological, cytological, immunohistochemical, and molecular diagnostics.
- Diagnosing transmissible spongiform encephalopathies in cattle, sheep, and goats.
- Detecting tetracycline in bone tissue of wild animals to monitor oral vaccination efforts.
- Collaborating with veterinary services and primary producers to control and monitor health status, offering expert opinions and recommendations to suppress and prevent both infectious and non-infectious diseases.
- Implementing reproduction control measures and addressing sterility issues on farms.
- Engaging in scientific and research endeavors through the execution of agreements with the Ministry of Science, Technological Development, and Innovation of the Republic of Serbia, as well as other scientific and research projects funded by domestic and international sources.
- Organizing training sessions for clinical, pathoanatomical, and laboratory diagnostics of diseases.